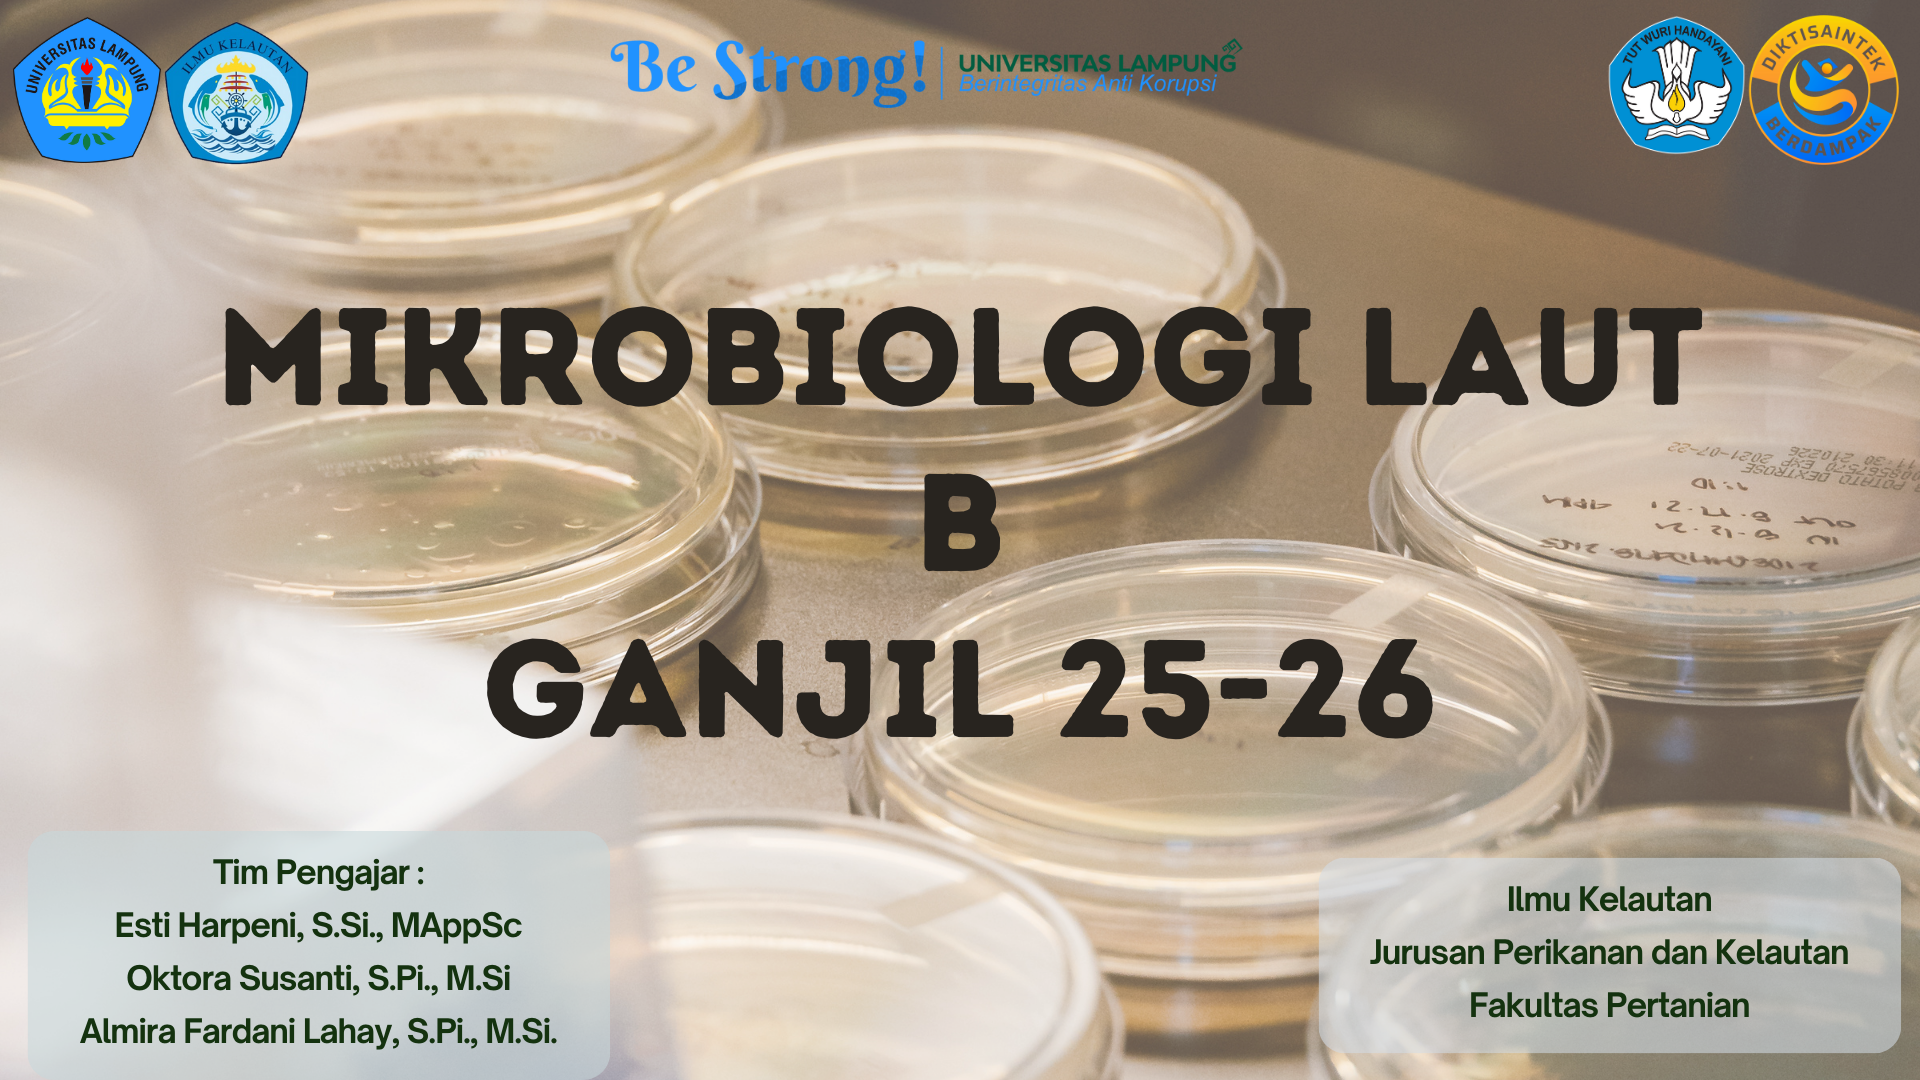
IKL B_Mikrobiologi Laut

ཐོ་བཀོད་ཀྱི་གདམ་ཁ།
Mata kuliah wajib pada Program Studi ilmu Kelautan. Mahasiswa akan mempelajari kelompok mikroorganisme; isolasi dan pewarnaan mikroorganisme; nutrisi mikroba; pertumbuhan mikroba; enzim; metabolisme mikroorganisme; dasar dasar biologi molekuler; konsep biologi molekuler; genetika mikroba; dan mikrobiologi terapan.
- སློབ་དཔོན: Esti Harpeni
- སློབ་དཔོན: Almira Lahay
- སློབ་དཔོན: Oktora Susanti
- སློབ་ཕྲུག་ཚུ་ཐོ་བཙུགས་འབད་ཡོདཔ: 24